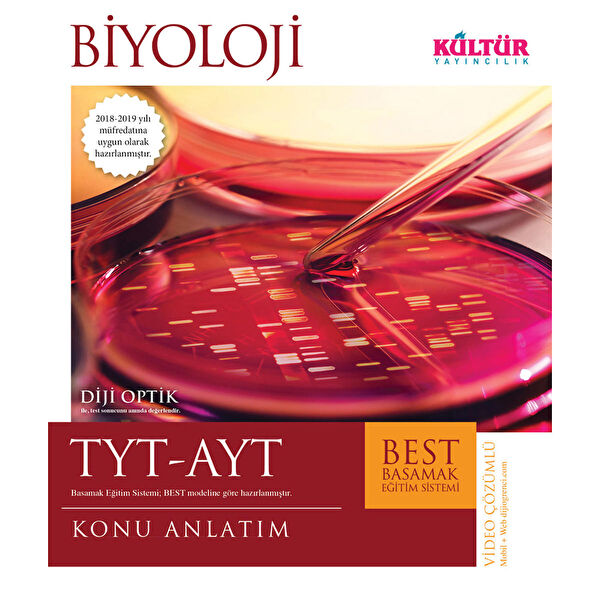
Kültür Yayıncılık Sınav Hazırlık

-
Anasayfa
-
Kitap, Kırtasiye, Hobi, Oyuncak
-
Kitap
-
Eğitim Kitapları
-
Sınav Hazırlık Kitapları
- Kültür Yayıncılık Sınav Hazırlık Kitapları
Kültür Yayınları TYT AYT Biyoloji Best Konu Anlatım
Kültür Yayıncılık

Tüm Ürün Açıklamasını Gör
325,00 TL
Son 30 Günün En Düşük Fiyatı
259,00 TL
Ürün Açıklaması
Ürün Özellikleri
Sınav Türü
TYT-AYT
Yayınevi
Kültür Yayıncılık